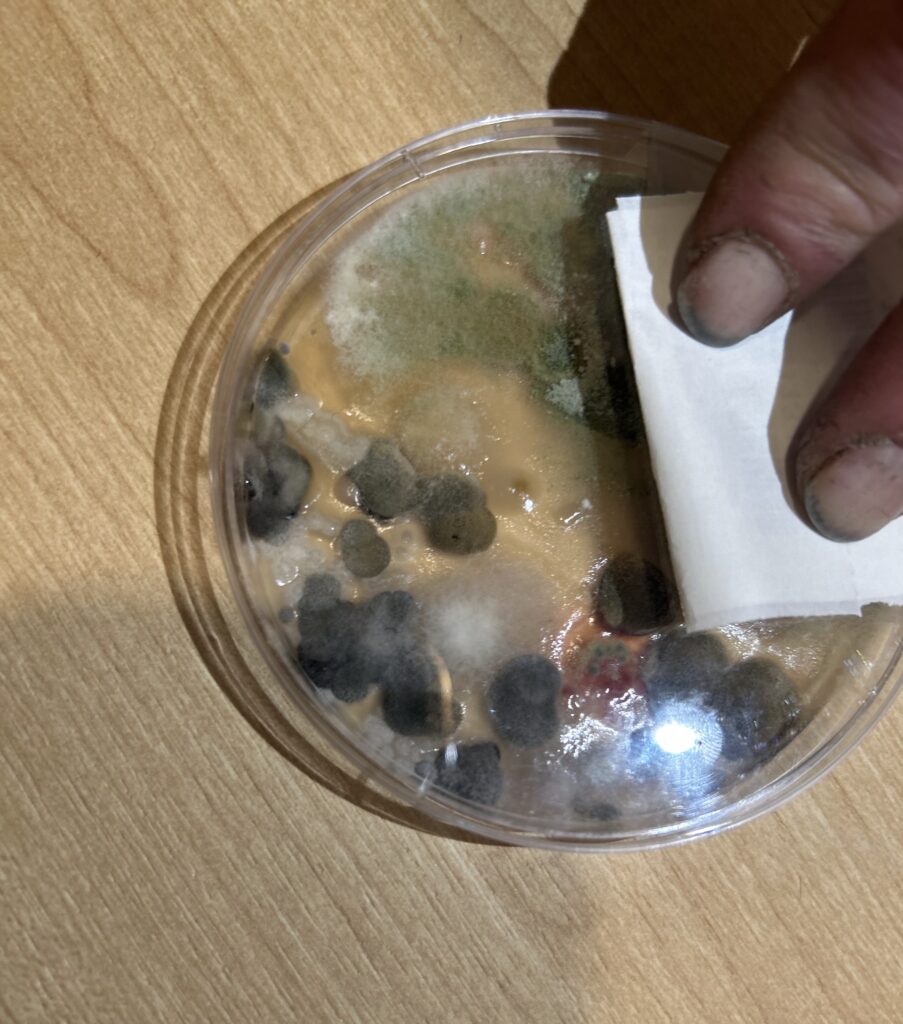

When San Jose’s first multi-story, modular housing site opened in February, it was hailed as an inexpensive, cutting-edge solution to end homelessness.
But within months, cracks in the infrastructure at 1 Branham Lane began to show. Shower benches had fallen out, leading to injury, water from some apartments emitted a sewage smell, walls had water damage and multiple residents said they felt nauseous in their apartments. San José Spotlight reviewed photos and videos of the issues and spoke with six residents, with most asking for anonymity for fear of retaliation.
As a result of the issues, one resident filed a lawsuit in Santa Clara County Superior Court against the city citing unsafe living conditions.
In the lawsuit filed May 29, April, who asked to only be identified by her first name for privacy reasons, said Branham Lane has mold contamination, poor ventilation and shower benches that weren’t installed properly, among other problems. She claims the city did not take action to enforce safety standards, putting residents’ health at risk. April said she is suing the city and not the developer DevCon, which oversaw the project, or nonprofit LifeMoves, which manages the building, because she wants oversight.
San Jose filed a July 1 response, saying the city “lacks sufficient information and belief as to the allegations therein.”
Branham Lane is a three-story modular building with 168 apartments equipped with a kitchen, bathroom, air conditioning and heat. It’s received nearly $52 million from the state through Project Homekey, $4 million from Santa Clara County, $5 million from the Sobrato Foundation and nearly $39 million in city dollars, spread out over seven years.
Residents feel sick
Soon after April moved into an apartment in the spring, she began to experience difficulty breathing. She said it felt like inhaling needles and there was a strong, earthy smell inside her apartment. She slept outside on her mattress for two days and felt her symptoms dissipate.
“I (was) so sick,” April told San José Spotlight.
April suspected the earthy smell might be a result of mold. She bought an in-home mold test kit from Home Depot to test the air inside her apartment. Within days, what appeared to be mold spores started to collect in the petri dish, showing blotches of black and green, according to photos reviewed by San José Spotlight. Another resident who wished to remain anonymous due to fear of retaliation said there is a strong mildew smell coming out the bathroom from their apartment.
Lifemoves spokesperson Maria Prato said they contacted a licensed environmental firm to conduct mold testing.
“That assessment detected no concerning or elevated levels and indicated no remediation is required,” Prato told San José Spotlight. “We’ve continued broader site testing and will coordinate with the city of San Jose and our design-builder if any action is needed.”
The nonprofit provided April with a HEPA filter and also offered to move her into another apartment out of caution, according to a LifeMoves letter addressed to April viewed by San José Spotlight.
April said she felt nauseous inside the new apartment because it smelled like rotten eggs. She returned to her old one, opting to sleep with her door open. April said she can breathe better since removing the insulation from a vent on her floor.
Another resident at Branham Lane told San José Spotlight he feels nauseous in his apartment, and on some nights sleeps in his car. A third resident said they have experienced dizziness and shaking, something they hadn’t previously dealt with before moving to Branham Lane.
Prato said testing found “no harmful mold or any other contaminants” and that LifeMoves regularly inspect apartments for potential health hazards.
“Clients who have health or safety concerns are offered — or can request — alternate accommodations, either to another on-site unit through LifeMoves or to an alternate facility entirely through the Santa Clara County Office of Supportive Housing referral and placement system,” Prato said.

Shoddy construction
In May, another resident said she was sitting on a shower bench when it collapsed after the first use. She sustained a head and shoulder injury, and continues to be in pain due to the fall, she told San José Spotlight.
Prato confirmed one shower-related injury and said medical care is offered to anyone injured on-site. Since that incident, LifeMoves received another maintenance request for a shower bench, and started supplying its disabled clients with standalone shower chairs, she said.
April’s lawsuit documents more instances of compromised shower benches. Photos viewed by San José Spotlight showed one bench with the screws coming out, and another where the wall holding up the bench had cracks.
LifeMoves is coordinating a site-wide audit of the shower benches with its building partners, Prato said.
In addition, multiple residents told San José Spotlight their water smells foul, and refuse to drink it.
Prato said that LifeMoves investigated these concerns immediately and found standing water in the water heaters was causing the smell. They have flushed affected buildings and the water provider has told them the water supply is “safe for drinking and bathing,” she said.
However, multiple residents say their water has continued to smell like sulfur or sewage and none of the building partners or the city have taken responsibility.
Brice Schilling, Devcon senior project manager, said the plumbing system underwent a complete chlorination treatment before residents moved in.
“Devcon stands behind all of our projects, and we’ll always do what is required to fix any problems that are brought to our attention,” Schilling told San José Spotlight. “In this case, neither LifeMoves nor the city have made us aware of any habitability issues.”
Volumetric Building Companies, the subcontractor responsible for constructing the modular apartments before being brought onsite, said they were properly constructed.
“Our units were designed and built with proper blocking and supports for shower benches, ventilation was designed and built to conform with the code requirements and the units were delivered dry and in good condition,” CEO Vaughn Buckley told San José Spotlight. “I do understand that some units were renovated after VBC delivered them, due to water infiltration while the (general contractor) was performing work to complete the buildings on site. You would have to speak to those that restored our units to determine what was done, or if anything was modified during that process.”

San José Spotlight first reported in March 2024 how Branham Lane’s factory-made homes arrived unfinished in October 2023 and grew mold after sitting out in the rain for weeks.
Months later, officials documented deficiencies in the dwellings’ factory-installed waterproofing, as well as faulty installation of exterior protective finish. Meanwhile, the city’s Planning, Building and Code Enforcement Department found critical firewall separations missing, which are meant to prevent fire from spreading, as well as plumbing errors made during factory construction.
Schilling said the development was remediated of mold prior to people moving in.
San José Spotlight reviewed a post-mold remediation report of April’s apartment prepared by Forensics Analytical Consulting Services. It deemed the apartment “cleared” and found “no remaining visible mold growth” was evident.
Poor ventilation
The windows can’t open in Branham Lane and some apartments don’t have a proper ventilation system, according to multiple residents and a city inspection report viewed by San José Spotlight.
A city housing department building inspector checked three apartments on May 20 and found deficiencies in two of the apartments air ventilation systems. April’s apartment appeared to lack a ventilation system, according to the report. The second apartment’s ventilation system initially wasn’t working but was fixed by a resident, and a third had water damage.
The inspector recommended an independent contractor be brought to April’s apartment to evaluate the problem. April said no independent contractor has come to her apartment.
A housing department spokesperson said the ventilation systems seemed to be working properly when the inspector did a walk-through of the property.
“While not all units were checked, systems appeared to operate properly at all inspected units,” Sarah Fields, housing department spokesperson, told San José Spotlight. “Any further information on the property (energy ventilation) systems should be directed to the project general contractor.”
Schilling said DevCon was not responsible for the design or installation of HVAC or exhaust systems.
“The design was prepared by registered California engineers hired by the module manufacturer, and subsequently approved by an independent Design Approval Agency certified by the state of California,” Schilling said. “Based on the approved designs, the modular units were manufactured with sufficient air intake and exhaust.”
However, multiple residents say they find it difficult to breathe inside their apartments.
“I can tell the difference between outside and inside,” David, who has worked in construction for decades and asked not to use his last name for privacy reasons, told San José Spotlight.
He said the air inside his apartment irritates his lungs and throat. Every morning and night he wakes up coughing, and often has a sore throat — something he hasn’t experienced in other places he’s lived. David said he runs his air conditioning every day to get better circulation, but it recently broke.
“The place was just built recently, so nothing should be going down,” David said.
Despite these issues, the planning, building and code enforcement department provided a certificate of occupancy for Branham Lane prior to residents moving in.
When San José Spotlight asked code enforcement how the site passed inspections, a spokesperson deferred to the housing department. Fields confirmed the building received a certificate of occupancy on Feb. 10, but did not directly address the other problems residents are facing.
Even so, April said she would still rather have a place to live than be out on the streets as she is navigating health issues.
Mayor Matt Mahan’s office declined to comment and referred questions to city staff. Mahan initiated a policy to arrest homeless people who repeatedly refuse shelter.
“(Mahan’s) forcing people to choose between jail or living in unsafe and uninhabitable buildings that are not regulated by code enforcement,” April said.
Contact Joyce Chu at [email protected] or @joyce_speaks on X.


Leave a Reply
You must be logged in to post a comment.